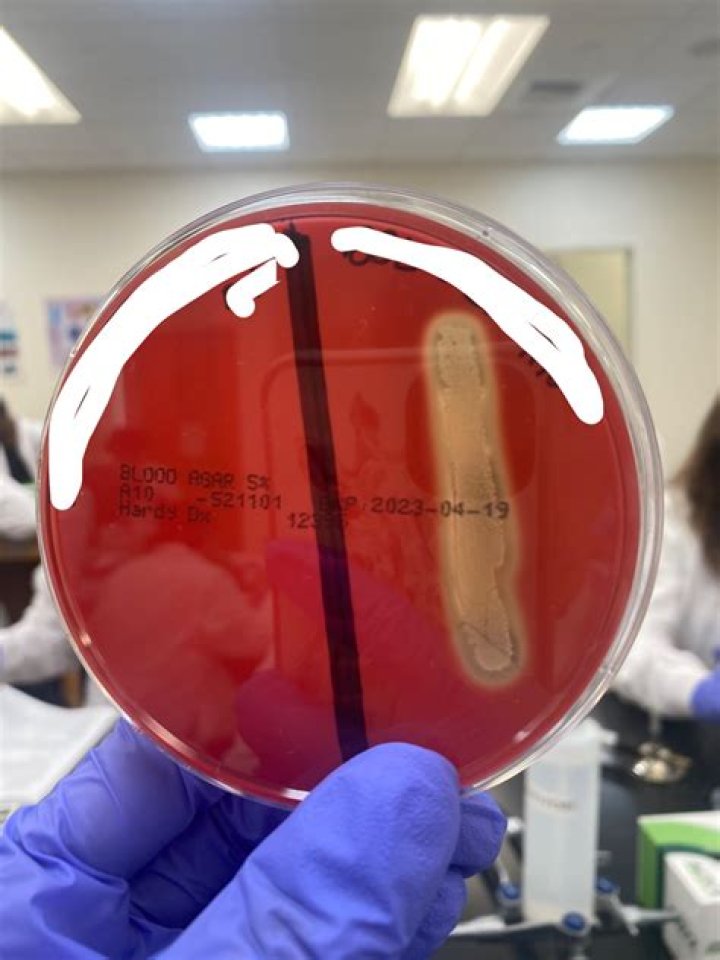

Is Alcaligenes faecalis hemolytic
faecalis is a Gram-negative bacterium which appears rod-shaped and motile under a microscope. It is positive by the oxidase test and catalase test, but negative by the nitrate reductase test. It is alpha-hemolytic and requires oxygen.
Is Alcaligenes faecalis pathogenic or nonpathogenic?
Alcaligenes faecalis is usually non-pathogenic, but cases of endocarditis, meningitis, peritonitis, and abscesses have been reported [26]. Most infections have been nosocomial, and most commonly occur in those who are immunocompromised as a result of contamination of hospital equipment [26].
Is Alcaligenes faecalis pathogenic beneficial or neutral?
Alcaligenes specie strains exist in soil, water, and environment, as well as in association with humans. The bacteria of this genus are usually non-pathogenic but occasional opportunistic infections could occur in humans.
Is Alcaligenes faecalis Halophile?
Alcaligenes=NOT a halophile.Does Alcaligenes faecalis produce endospores?
faecalis was isolated in 1896 by Petruschky from stale beer. Several strains of the organism have been found since then. This species is motile, flagellated, slender, slightly curved, not spore-forming, slowly growing, nonfermenting, capsule forming, Gram-negative aerobe of the family Alcaligenaceae.
Is Alcaligenes faecalis Bacillus?
(bacterium) Curved, straight or bean-shaped: bacilli come in many variants and are widely spread. Alcaligenes faecalis is a Gram-negative, rod-shaped bacterium with flagella, and belong to the family of Alcaligenaceae.
Is Alcaligenes faecalis aerobic or anaerobic?
Alcaligenes faecalis is a gram-negative rod with flagella belonging to the family of Alcaligenaceae. It is a nonfermentative aerobic, nonencapsulated, oxidase-positive bacterium and named for its ability to produce an alkaline reaction in certain medium [1].
Is Alcaligenes faecalis obligate Aerobe?
Alcaligenes faecalis is a Gram-negative, obligate aerobe, oxidase-positive, catalase-positive, and non-fermenting bacterium commonly found in soil, water, and hospital environments.Is Alcaligenes faecalis catalase-positive or negative?
Alcaligenes faecalis (A. faecalis) is a Gram-negative, obligate aerobic, oxidase-positive, catalase-positive, and nonfermenting bacterium.
Is Alcaligenes faecalis arrangement?Alcaligenes faecalis occur in water and soil. The microbe has peritrichous flagellar arrangement which allows for motility (2). It is a gram-negative, rod-shaped organism observed at 0.5-1.0 μm x 0.5-2.6 μm in diameter.
Article first time published onIs Alcaligenes faecalis non Saccharolytic?
piechaudii, and Alcaligenes faecalis (this organism remains in the genus Alcaligenes); the saccharolytic species A.
What is Alcaligenes faecalis resistant to?
Alcaligenes faecalis is generally resistant to aminoglycosides, chloramphenicol and tetracyclines and usually susceptible to trimethoprim–sulfamethoxazole and β-lactam antibiotics such as ureidopenicillins, ticarcillin–clavulanic acid, cephalosporins and carbapenems.
Does Alcaligenes faecalis grow on MacConkey Agar?
Can grow on MacConkey agar and Simmons’ citrate agar. Isolated from soil, water, feces, urine, blood, sputum,wounds, pleural fluid, nematodes, and insects. Subsp.
Is a faecalis pathogenic?
Some pathogenic bacteria belong to a large, diverse group of species capable of infecting plants, animals, and humans. Enterococcus faecalis is an opportunistic human pathogen capable of infecting patients with a deficient immune system.
Does Alcaligenes faecalis produce amylase?
Characterization of Alcaligenes faecalis GPA-1 producing thermostable extracellular α-amylase.
Where are Alcaligenes faecalis found?
Alcaligenes faecalis was first discovered in feces, and is commonly found in soil, water, and other environments (14–16). Currently, this bacterium has wide applications in the sewage treatment and pharmaceutical industries.
Does Alcaligenes faecalis hydrolyze gelatin?
Basic CharacteristicsProperties (Alcaligenes faecalis subsp. faecalis)Gelatin HydrolysisNegative (-ve)Gram StainingGram-negative (-ve)Growth in 7% NaClPositive (+ve)H2SNegative (-ve)
Is Alcaligenes faecalis obligate anaerobe?
A bacillus which is a motile, non-nitrate reducing, oxidase positive, catalase positive, and citrate positive gram-negative obligate aerobe that colonises humid areas in hospitals and may transiently colonise the skin.
Is Alcaligenes faecalis Aerotolerant?
Strict aerobes will only grow near the surface of the agar (Af, Alcaligenes faecalis; Pf, Pseudomonas fluorescens). Aerotolerant anaerobes grow at the same rate in presence or absence of oxygen (Lp. Lactobacillus plantarum).
Does Alcaligenes faecalis produce acid?
R-(-)-Mandelic acid was produced from racemic mandelonitrile by Alcaligenes faecalis ATCC 8750. Ammonium acetate or L-glutamic acid as the carbon source and n-butyronitrile as the inducer in the culture medium were effective for bacterial growth and the induction of R-(-)-mandelic acid-producing activity.
How common is Alcaligenes faecalis?
faecalis were less than 50%. Conclusions: The most frequent Alcaligenes faecalis infection sites, in order, are the bloodstream, urinary tract, skin and soft tissue, and middle ear. The susceptibility rate of Alcaligenes faecalis to commonly used antibiotics is decreasing.
How is Alcaligenes faecalis spread?
Alcaligenes faecalis is a gram-negative bacterium that is commonly found in the environment. This pathogen is usually transmitted in the form of droplets through ventilation equipment and nebulizers, but transmission through direct contact has also been documented in few case reports.
Is Alcaligenes faecalis nitrate positive or negative?
Alcaligenes faecalis is a Gram-negative heterotrophic bacterium that is common in soil (1). A. faecalis was reported to aerobically produce nitrite (NO2−), nitrate, nitric oxide (NO), and nitrous oxide in both peptone-meat extract and defined media with ammonium and citrate as the sole nitrogen and carbon sources (2).
Is Alcaligenes faecalis motility?
Alcaligenes faecalis is a Gram-negative catalase- and oxidase-positive, motile rod. It is commonly found in a watery environment and is rarely isolated from humans.
Is Escherichia coli gram positive or negative?
Escherichia coli (E. coli) is a Gram-negative, rod-shaped, facultative anaerobic bacterium.
Does a faecalis ferment lactose?
faecalis can grow in the presence of bile salts. … faecalis can be cultivated on purple agar and ferments lactose under acid production (see Fig.
Is Clostridium Sporogenes an obligate anaerobe?
Clostridium sporogenes ATCC 3584 is an obligate anaerobe that has been reported to possess excellent tumour-targeting capacity.
Is Enterococcus faecalis hemolytic?
E. faecalis are non-hemolytic on sheep blood agars but are beta-hemolytic on media containing rabbit, horse and human blood.
Is Alcaligenes faecalis normal flora?
Alcaligenes faecalis is a gram-negative organism that is commonly found in the environment and may also be a part of normal fecal flora in humans.
What does it mean if a microorganism is non Saccharolytic?
Define: Non-saccharolytic. produce no acids under either aerobic or anaerobic conditions; cannot utilize carbohydrates.
Is a faecalis oxidative or fermentative?
CharacteristicsEnterococcus faecalisOF (Oxidative/Fermentative)–IndoleNegative (-ve)CitrateNegative (-ve)UreaseNegative (-ve)



